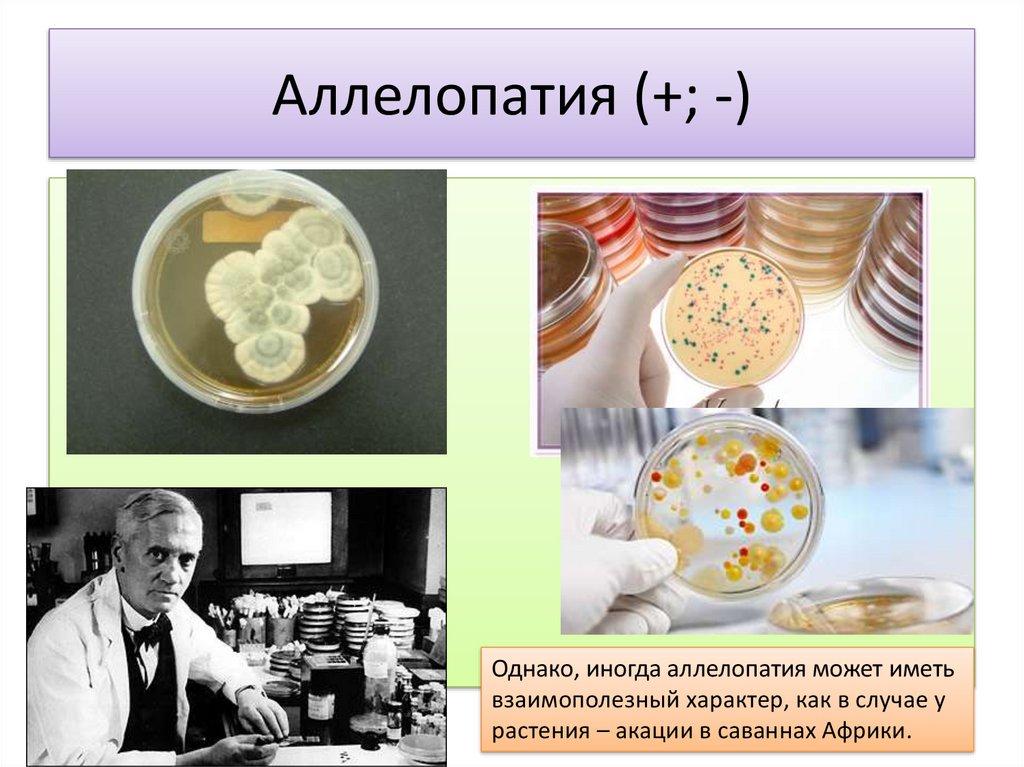

Похожие презентации:
Виды взаимоотношений между организмами
1. Виды взаимоотношений между организмами
2. Биотические факторы окружающей среды
БИОТИЧЕСКИЕ ФАКТОРЫОКРУЖАЮЩЕЙ СРЕДЫ
Топические
• по изменению среды (разрывание почвы)
Трофические
• пищевые отношения (продуценты, консументы, редуценты)
Фабрические
• по жилищу (паразитические черви используют организм как среду
обитания)
Форические
• по переносу (рак отшельник переносит актинию)
3.
4.
Нейтрализм (0 0) - это такиевзаимоотношения, при которых живые
организмы не оказывают друг на друга
никакого взаимного влияния.
5. Нейтрализм (00)
Белка и лось6. Нейтральные отношения. Нейтрализм (0; 0)
Белый грибСокол - сапсан
7.
Конкуренция( - -) – взаимовредныеотношения между живыми организмами,
обладающими сходными потребностями
8. Конкуренция (- -)
КОНКУРЕНЦИЯ (- -)Если два и более
вида обладают
сходными
экологическими
требованиями и
обитают совместно,
между ними может
возникнуть
конкуренция, от
которой страдают
оба вида (- -).
9. Конкуренция(--)
Борьба за существование, за доминирование, за пищу,пространство и другие ресурсы между организмами
или популяциями
Суслики и овцы конкурируют в пределах одного пастбища
10. Взаимно-вредные (--)
Внутривидовая конкуренция11. Взаимно-вредные (--)
Межвидовая конкуренция12.
13. Взаимовредные отношения Конкуренция (-;-)
Овсюги конкурируют с культурным овсом14. Аменсализм (- 0)
АМЕНСА ЛИЗМ (- 0)Для одного, из
совместно
обитающих видов,
влияние другого вида
отрицательно, в то
время как
угнетающий не
получает ни вреда,
ни пользы (-0).
15. Вредно-нейтральные (-0) – аменсализм
Деревья и светолюбивые травы16. Аменсализм (-; 0)
Сосна и сфагнум17. Комменсализм (+ 0)
КОММЕНСА ЛИЗМ (+ 0)Форма
взаимоотношений,
при которой один вид
получает какое-либо
.
преимущество, не
принося другому ни
вреда, ни пользы
(+0).
Человек и чешуйница
Например, крупные млекопитающие (собаки, олени) служат
разносчиками плодов и семян с зацепками (вроде репейника), не
получая от этого ни ущерба, ни преимуществ
18.
Комменсализм (+0)Черепаха и рыбы-прилипалы
19.
20. Нахлебничество +; 0 (разновидность комменсализма)
Гиены и лев21. Полезно-нейтральные (+0)
Нахлебничество22.
23. Комменсализм (+ ; 0) (сотрапезничество)
Горох – выделяет впочву соединения азота.
Рожь
24.
25. Квартиранство +; 0 (разновидность комменсализма)
Горчак (сем.Карповые)
откладывает икру
в мантийную
полость
моллюска.
26. Полезно-нейтральные (+0) -комменсализм
Полезно-нейтральные (+0) комменсализмКвартиранство
27. Симбиотические взаимоотношения (++)
СИМБИОТИЧЕСКИЕВЗАИМООТНОШЕНИЯ (++)
В природе часто
встречаются
взаимовыгодные
связи между видами
организмов, при
которых они
получают обоюдную
пользу (++).
К ним относятся
протокооперация и
мутуализм.
28. Протокооперация (+ +)
ПРОТОКООПЕРАЦИЯ (+ +)Буквально: первичное
сотрудничество (++). В
этом случае
совместное
существование
выгодно для обоих
видов, но не
обязательно для них, т.
е. не является
непременным
условием их
выживания.
29. Протокооперация (+;+)
Перенос семян муравьями. Среди губановыхимеются рыбы-чистильщики, освобождающие
крупных рыб от наружных паразитов,
находящихся на коже, в жаберной и ротовой
полостях.
30.
31. Взаимно-полезные (++) -
Взаимно-полезные (++) Протокооперация32. Мутуализм
МУ Т УА ЛИЗМБолее тесные
взаимовыгодные
отношения, при
которых присутствие
каждого из двух
видов становится для
другого
обязательным (++).
33.
Самая тесная форма мутуализма — когда один организм живётвнутри другого. Поразительным примером этого служит система
органов пищеварения коров и других жвачных животных. Коровы,
как и человек, не способны переварить целлюлозу — вещество,
которое в большом количестве содержится в растениях. Но у жвачных
животных есть особый орган — рубец. Он представляет собой
полость, в которой живут множество микробов. Растительная пища,
после того как животное её прожевало, попадает в рубец, и там эти
микробы разрушают целлюлозу. (Животное может отрыгнуть и вновь
прожевать частично расщеплённую пищу — именно этим и
занимаются коровы, когда пережёвывают свою жвачку.) Рубец
коровы — это замкнутая микроэкосистема, образованная
множеством различных микроорганизмов, которые питаясь сами
перерабатывают целлюлозу для своего хозяина. Аналогично
корневая система высших растений образована переплетением
корневой ткани и грибных нитей, так что грибы, получая питание от
растения, снабжают его минеральными веществами.
34. Акула и рыба - чистильщик
35. Мутуализм (+; +) . Актиния «жалит» добычу, а рак ее съедает, пища (остатки) достается и актинии тоже.
36. Взаимно-полезные (++)
Мутуализм37. Мутуализм (+;+)
38.
• В нашем собственном организме существуют сотниразличных видов бактерий, которые живут в толстом
кишечнике. Большинство из них мало изучены, но мы
знаем много о кишечной палочке ( E. col ), которая
является одной из нормальных бактерий,
встречающихся в толстых кишечниках всех людей
• Люди обеспечивают E. coli едой и местом для жизни. В
свою очередь, кишечная палочка производят витамин
К, и затрудняет проникновение патогенных бактерий в
наш кишечник. Пока доскональна неизвестно,
участвуют ли другие бактерии нашего
пищеварительного тракта в абсорбции или
производстве витаминов, но все они препятствуют
развитию патогенов внутри нас.
39.
• Термиты могут есть только древесину,потому что в их кишечнике есть
мутуалистические простейшие и бактерии,
которые помогают им переваривать
целлюлозу.
40.
• Удивительным примером немного жуткого, ноочень интересного симбиоза, является взаимосвязь
гриба Кордицепса и насекомых. К примеру, споры
зомби-гриба присоединяются к муравью и
проникают в его ткани с использованием
ферментов. После этого, гриб изменяет поведение
муравья и подчиняет его. Муравей удаляется от
своей колонии, поднимается по стволу растения и
неестественно помещает свои жвала глубоко в лист.
После прикрепления к листку, муравей теряет
способность передвигаться, и гриб начинает расти
из его тела. Таким образом находясь на высоте,
зомби-гриб наиболее эффективно распространяет
свои споры.
41.
42. Акация бычерогая и муравьи
43. Симбиоз
• Слово симбиоз буквально означает "житьвместе", но когда мы используем слово
симбиоз в биологии, мы действительно
говорим о тесном, долгосрочном
взаимодействии между двумя разными
видами.
44. Симбиоз (+;+)
Существование каждого из них поодиночкестановится невозможным.
45.
46.
Уснея(Usnea)
47.
48.
49.
50. Паразитизм (+; -) иногда (+; +)
Языковая мокрицаВ последнее время многие
ученые экологи рассматривают
паразитизм как форму
симбиотических отношений.
Паразит проникает через
жабры и прикрепляется к
основанию языка пятнистого
розового люциана .
51. Полезно-вредные (+-)
хищничество52. Антибиотические отношения. Хищничество (+;-)
53.
54. паразитизм
ПАРАЗИТИЗМЭто форма
биотических
отношений, при
которых организмы
одного вида (паразита)
живут за счет
питательных веществ
или тканей организма
другого вида (хозяина)
(+-). Паразитизм
можно рассматривать
как ослабленную
форму хищничества
55.
Паразитизм56. Суперпаразитизм
Наездник - суперпаразит57.
Паразитизм – это взаимоотношения, прикоторых одни живые организмы живут за счёт
потребления питательных веществ и органов
или тканей других организмов
58.
Паразитизм59. Полезно-вредные (+-)
Грибы - паразиты60. Полезно-вредные (+-)
Растения - паразиты61. Полезно-вредные (+-)
Животные - паразиты62. Полезно-вредные (+-)
Разновидность хищничества – каннибализм63. Аллелопатия (+; -)
Однако, иногда аллелопатия может иметьвзаимополезный характер, как в случае у
растения – акации в саваннах Африки.
64. Выводы
В процессе эволюции между организмами возниклисложные взаимоотношения.
2. Биотические факторы влияют не только на отдельные
особи, но и на популяцию в целом, регулируя численность
видов.
3. Взаимоотношения между организмами различных
систематических групп обеспечивают биологическое
равновесие в экосистеме.
4. Хотя взаимодействия организмов очень разнообразны,
они приводят лишь к трем главным результатам:
обеспечению пищей,
изменению среды обитания,
расселению видов в пространстве.
5. Биотические взаимоотношения чрезвычайно сложны и
по-разному протекают в различных условиях. Это делает их
труднопредсказуемыми.
1.
65.
Вид взаимоотношенийНейтрализм
Аменсализм
Внутривидовая конкуренция
Межвидовая конкуренция
Протокооперация
Мутуализм
Нахлебничество
Квартиранство
Хищничество
Паразитизм
Вид взаимоотношений (+ -)
66. Биологическая задача 1
Иногда можно услышать мнение: «Неужелисовременные техника и наука не может
найти средств для уничтожения комаров?
От них столько неприятностей людям и
животным!» Представим себе, что такое
средство найдено. Правильно, ли поступит
человек, если воспользуется им? Почему?
67. Биологическая задача 2
Личинкамайского
жука
питается
перегноем, корнями трав и деревьев, а
взрослый жук – листьями деревьев. Какое
приспособительное значение для майских
жуков имеют эти различия в питании?
68. Задание
Определите тип отношений актинии и рыбыклоуна
Мутуализм (+;+)

Биология
Биология








